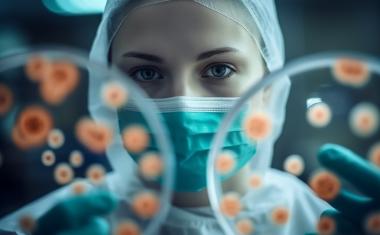

Umicore erwirbt Technologien und Services von Solvias
Umicore Precious Metals Chemistry (Umicore PMC) hat den Erwerb von Hochdurchsatz-Screening (HTS)- und speziellen Ligandentechnologien von Solvias vereinbart.

Umicore Precious Metals Chemistry (Umicore PMC) hat den Erwerb von Hochdurchsatz-Screening (HTS)- und speziellen Ligandentechnologien von Solvias vereinbart.

Die Herstellung von Wasserstoff aus lokal verfügbarer Biomasse gilt als wichtiger Baustein für eine nachhaltige Energieversorgung.

Die Verbindung von technologischer Exzellenz und nachhaltigen Lösungen wird immer mehr zum Erfolgsfaktor für BASF. Beispiele aus der BASF-Forschung verdeutlichen, wie innovative Technologien die Chemie- und Agrarindustrie revolutionieren können und nicht nur unmittelbare Wettbewerbsvorteile, sondern auch Impulse für die nachhaltige Transformation der Industrie bieten.

Die Wasserstoffwirtschaft befindet sich im Wandel: Der Übergang von grauem zu grünem und blauem Wasserstoff stellt neue Anforderungen an die Gasreinigung.

HTE unterzeichnete einen Vertrag mit Mitsubishi Chemical, um Forschungsdienstleistungen für das Screening von MMA-Oxidationskatalysatoren durchzuführen.

Edelmetallkreisläufe werden für viele industrielle Verarbeiter und Anwendungen immer wichtiger

BASF liefert Schlüsselmaterialien für effiziente Wasserstoffreinigung, einschließlich Lösungen zur Entfernung von Sauerstoff und Wasser.

Die Tochtergesellschaft Smoltek Hydrogen des Nanotechnologieunternehmens Smoltek und Heraeus Precious Metals kündigen eine strategische Zusammenarbeit an, um die Funktionseffizienz poröser Transportschichtelektroden (PTEs) in Protonenaustauschmembran (PEM)-Elektrolyseuren auf ein neues Niveau zu heben.

Die Unternehmen werden sich zunächst auf Katalysatoren mit niedrigem Iridiumgehalt konzentrieren, um damit Kosten zu senken und Lieferengpässe zu verringern.

Katalysatoren und Sauerstoffverzehrkathoden

Ferdi Schüth, Direktor und wissenschaftliches Mitglied am Max-Planck-Institut für Kohlenforschung in Mülheim an der Ruhr, wird für seine herausragenden Arbeiten in der Katalyseforschung mit dem Alwin Mittasch-Preis 2025 ausgezeichnet.

BASF hat das neue Katalysator- und Feststofftechnikum in Ludwigshafen eingeweiht. Mit dem Forschungstechnikum wird das Chemieunternehmen Chemiekatalysatoren im Pilotmaßstab herstellen und damit seinen Kunden weltweit in Zukunft schneller innovative Technologien anbieten können. Zudem werden dort neue Verfahren und Prozesse für die Verarbeitung und Herstellung von Feststoffen entwickelt.

BASF kündigte Pläne an, in zusätzliche Produktionskapazitäten für ihre X3D-Technologie zu investieren, eine neue additive Fertigungsmethode für Katalysatoren, die auf 3D-Druck basiert. Die Anlage, in der Katalysatoren im industriellen Maßstab hergestellt werden sollen, wird voraussichtlich 2026 in Betrieb gehen.

Ravindra Heraeus erwirbt den Standort in Vizag von Arora Matthey. Der dortige Betrieb ist auf die Produktion und das Recycling von Edelmetallkatalysatoren spezialisiert.

Vorstellung des Einsatzes heterogener Edelmetallkatalysatoren zur Feinreinigung von Wasserstoff als gängiges, leicht umsetz- und skalierbares Verfahren.

Die pharmazeutische Industrie befindet sich zunehmend im Wandel von Batch-Verfahren hin zu kontinuierlichen Prozessen, um Effizienz und Nachhaltigkeit zu verbessern.

Sechs Institute und Unternehmen erforschen unter der Konsortialführung von Heraeus Precious Metals den Einsatz von neuartigen Katalysatormodulen auf Basis von Kohlenstoff zur effizienteren und kostengünstigeren Bereitstellung von Wasserstoff aus grünem Ammoniak.

Das Treibhausgas CO2 als chemischen Rohstoff zu verwenden, würde nicht nur Emissionen, sondern gleichzeitig den Verbrauch fossiler Rohstoffe verringern. Eine neuartige metallfreie organische Gerüstverbindung könnte Wege eröffnen, Ethylen, eine der bedeutendsten Basischemikalien, elektrokatalytisch aus CO2 herzustellen.

Dechema-Geschäftsführer Andreas Förster über die Rolle von Chemietechnik und Biotechnologie für die Transformation zu einer nachhaltigen und klimaneutralen Industrie.

Ineratec und Sasol haben einen Fünfjahresvertrag über die Lieferung von Fischer-Tropsch-Katalysatoren unterzeichnet. Die von Sasol produzierten hochmodernen Katalysatoren nutzt Ineratec bei der Produktion von nachhaltigen e-Fuels etwa für die Luftfahrt.

Schnelles Screening allein reicht nicht für mehr Effizienz in der Katalyseforschung. Es gilt, den gesamten Forschungsprozess zu optimieren. Hier liegt das besondere Know-how des Heidelberger Unternehmens HTE.

Vier von fünf Chemikalien sind während ihrer Produktion mit Katalysatoren in Berührung gekommen.

BASF und die Universität Heidelberg werden weitere fünf Jahre zusammen im 2006 gegründeten Catalysis Research Laboratory (CaRLa) forschen. Beide Partner haben einen entsprechenden Vertrag unterschrieben und damit die erfolgreiche Forschungskooperation bis 2028 verlängert.

Özgül Agbaba, Postdoktorandin in der Abteilung für Heterogene Katalyse von Professor Ferdi Schüth am Max-Planck-Institut für Kohlenforschung in Mülheim an der Ruhr, hat einen Plan. Die junge Wissenschaftlerin ist dabei, ihr eigenes Start-up auf die Beine zu stellen.

Heraeus und Sibanye-Stillwater haben einen neuen, stabilen rutheniumbasierten Katalysator für die Protonenaustauschmembran (PEM)-Wasserelektrolyse entwickelt.

Clariant und die Technische Universität München (TUM) haben ihre langfristige strategische Allianz im Bereich der Forschung und Anwendung neuer Katalysatorsysteme erneuert.

Evonik hat die Verlagerung und Erweiterung seiner Anlage für Edelmetallpulverkatalysatoren im Shanghai Chemical Industrial Park (SCIP) abgeschlossen. Die Aufnahme der Produktion ist für das 4. Quartal 2023 geplant.
Heraeus hat eine antimikrobielle Technologie entwickelt, die Oberflächen und Textilien vor Keimen schützt und eine langanhaltende Wirkung gegen Bakterien, Viren, Biofilmbildung sowie multiresistente Keime zeigt.

BASF hat die Ausgliederung ihrer Geschäftseinheiten Mobile Abgaskatalysatoren und Edelmetall-Services abgeschlossen. Der Name der rechtlich eigenständigen Einheit lautet BASF Environmental Catalyst and Metal Solutions (ECMS).

Brenntag Specialties Pharma bietet einen maßgeschneiderten Service, der Enzyme in der Biokatalyse nachhaltig stabilisieren kann.

BASF eröffnet neues Zentrum für Wartungs-, Reparatur- und Überholungsservice von DeoxoTM Ozon- sowie Ozon-/VOC-Katalysatoren für Flugzeuge in Schanghai.

Die Biozidverordnung setzt die Farben- und Lackindustrie unter regulatorischen Druck:

Interview mit Roger Gläser von der Universität Leipzig zu aktuellen und zukünftigen Themen der Katalyseforschung.

Die SPRIND Challenges sind Innovationswettbewerbe, die zum Ziel haben, Lösungen für aktuelle gesellschaftliche und technologische Herausforderungen hervorzubringen. Auch die Chemie- und Pharmaindustrie kann von diesem neuen Instrument im deutschen Innovationsökosystem profitieren.

Die TU Darmstadt hat Professor Robert Schlögl mit der Ehrendoktorwürde ausgezeichnet. Der renommierte Chemiker wird damit für seine außerordentlichen Verdienste auf den Gebieten der heterogenen Katalyse und der Energiewende geehrt.












